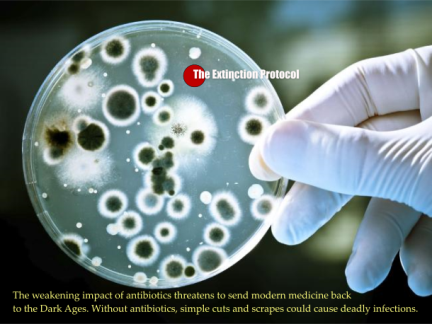

Ngày 27/5, Phó Tổng thư ký Liên Hợp QuốcStephen O'Brien đã kêu gọi các bên ngừng mọi hoạt động can thiệp vào việc viện trợ ở Syria.
Ngày 26/5, giới chức y tế và các nhà khoa học Mỹ thông báo đã ghi nhận trường hợp đầu tiên mắc siêu vi khuẩn kháng tất cả mọi loại kháng sinh. Họ cảnh báo sự lây lan của siêu vi khuẩn này sẽ là sự khởi đầu của "một cơn ác mộng" về một đại dịch bệnh nhiễm trùng vô phương cứu chữa trên toàn cầu.

Ngày 27/5, Thủ tướng Nhật Bản Shinzo Abe (Sin-dô A-bê) cho biết các nhà lãnh đạo Nhóm các nước công nghiệp phát triển (G7) đã nhất trí thực thi các chính sách tiền tệ, tài chính và cơ cấu giữa lúc các nước chung nhận định về khả năng một cuộc khủng hoảng kinh tế toàn cầu.

Trong hai ngày 26 và 27/5, tại Ise-Shima, tỉnh Mie (Nhật Bản), lãnh đạo các quốc gia công nghiệp phát triển (G7) và G7 mở rộng đã nhóm họp. Cuộc họp diễn ra trong bối cảnh tình hình thế giới có nhiều biến động, kinh tế toàn cầu tiếp tục trì trệ, các vấn đề an ninh, biến đổi khí hậu… đang đặt ra những thách thức lớn.

Các kênh thông tin chính thức Cuba vừa cho biết 2 văn kiện “Định nghĩa mô hình phát triển kinh tế-xã hội xã hội chủ nghĩa của Cuba” và “Kế hoạch phát triển kinh tế xã hội tới năm 2030: tầm nhìn, các trụ cột và các lĩnh vực chiến lược” mới được Đại hội Đảng VII thông qua sẽ được công bố toàn văn trong một chuyên san ngày 31/5.

Trong một bước đi nhằm gây sức ép với Quốc hội do phe Cộng hòa toàn quyền kiểm soát, ngày 2/5, Tổng thống Mỹ Barack Obama nói rằng việc Trung Quốc đang thúc đẩy Hiệp định Đối tác Kinh tế Toàn diện Khu vực (RCEP) làm nổi bật sự cấp bách của việc Quốc hội Mỹ phê chuẩn Hiệp định Đối tác xuyên Thái Bình Dương (TPP).

Đại hội lần thứ 7 của Đảng Lao động Triều Tiên sáng 6/5 khai mạc tại thủ đô Bình Nhưỡng của Triều Tiên.

Trong hai ngày 6-7/5, tại cố đô Luang Prabang (Luông Phạ-bang) của Lào đã diễn ra các Cuộc họp Quan chức cao cấp (SOM) của các nước thành viên Hiệp hội các quốc gia Đông Nam Á (ASEAN), ASEAN+3 (gồm Hàn Quốc, Nhật Bản và Trung Quốc) và Hội nghị Cấp cao Đông Á (EAS). Đoàn Việt Nam do Thứ trưởng Ngoại giao Lê Hoài Trung làm Trưởng đoàn đã tham dự các cuộc họp.

Cuộc họp dành nhiều thời gian trao đổi về các vấn đề khu vực và quốc tế cùng quan tâm như tình hình Bắc Triều Tiên, Biển Đông, Ukraine, chống khủng bố...

Sáng 10/5, tại thủ đô Vientiane, Học viện Chính trị Quốc gia Hồ Chí Minh đã phối hợp cùng với Học viện Chính trị Hành chính Quốc gia Lào tổ chức Lễ triển khai Dự án “Biên dịch Hồ Chí Minh toàn tập từ tiếng Việt sang tiếng Lào.”